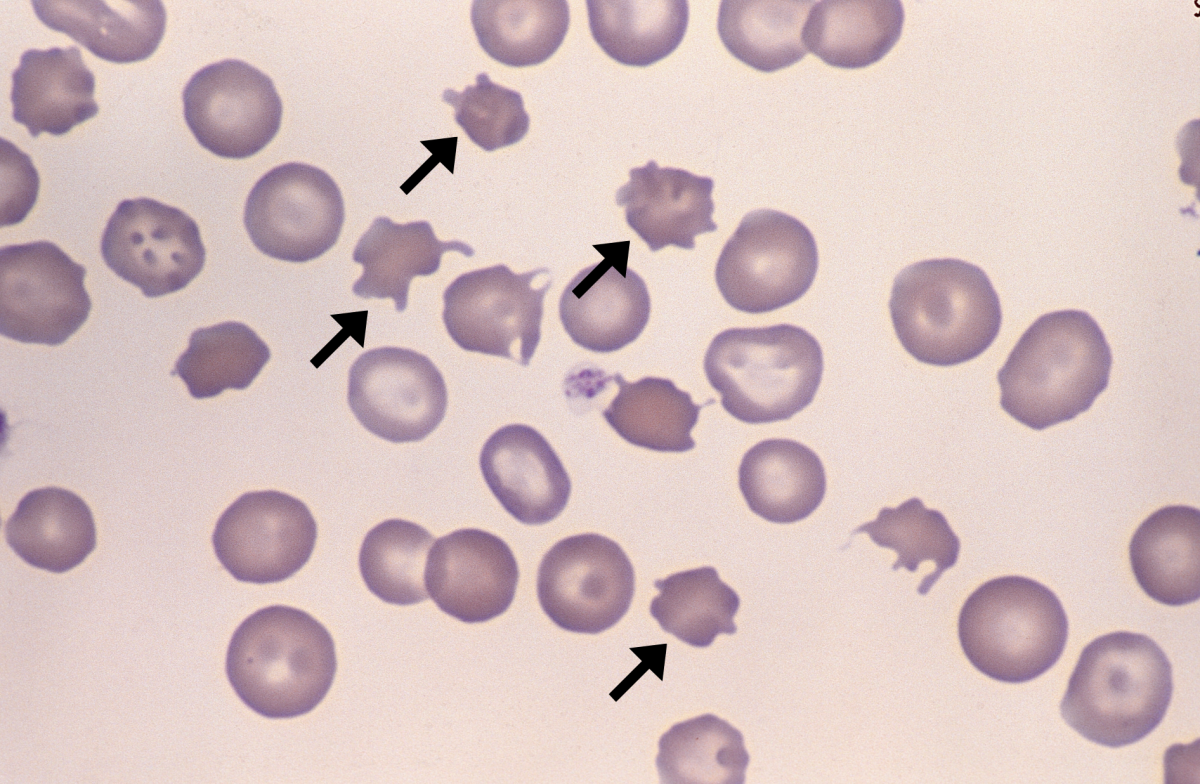
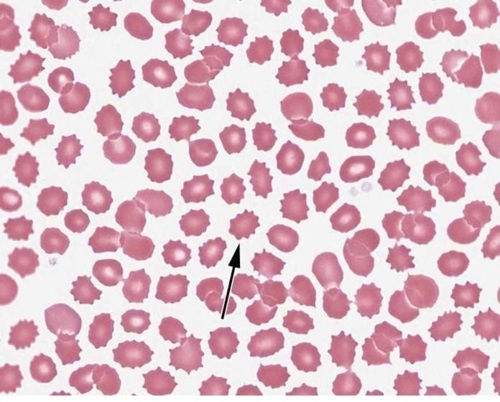

RBC morphology RBC morphology
0.0(0)
0.0(0)
New
Card Sorting
1/5
There's no tags or description
Looks like no tags are added yet.
Study Analytics
Name | Mastery | Learn | Test | Matching | Spaced |
|---|
No study sessions yet.
6 Terms
1
New cards

Ovalocyte/elliptocyte
Altered membrane
2
New cards

Sickle cell
Abnormal globin chain structure caused by 1 single amino acid rearrangement
3
New cards
Acanthocyte
Increased cholesterol
4
New cards
Echinocyte
Cation imbalance; change in tonicity
5
New cards

Schistocyte
Fragmented by fibrin
6
New cards

Tear drop
Enlarged spleen